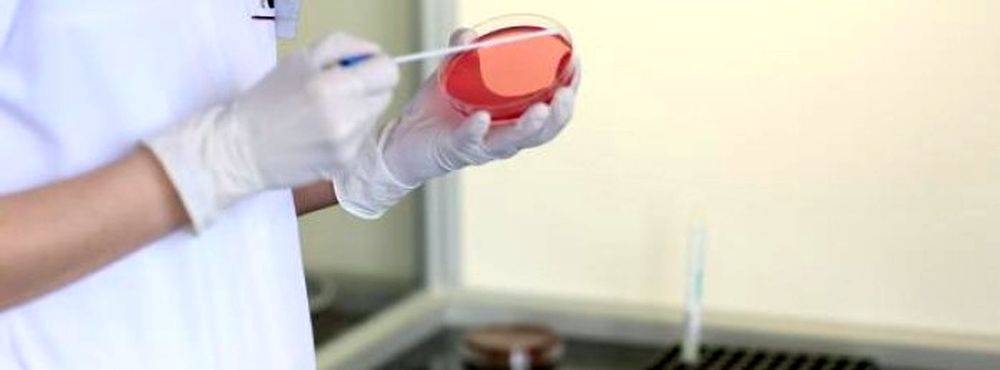

Romániában az elmúlt héten több mint hétszázzal nőtt a kanyaróban szenvedő betegek száma, ami csaknem négyszerese az elmúlt kilenc hét átlagának.
2017. április 14., 18:162017. április 14., 18:16
2017. április 14., 18:572017. április 14., 18:57
A román közegészségügyi hatóság pénteki közlése szerint 4 793 beteget tartottak nyilván a hatóságok, ebből 21-en meghaltak. A legtöbb, 5-5 halálos esetet Arad, Temes és Dolj megyében jegyezték. Legutóbb kedden jelentettek két halálesetet a bukaresti hatóságok.
Az elmúlt héten Szeben megyében nőtt meg látványosan, 37-ről 170-re a betegek száma, és ezzel a dél-erdélyi megye a 17. helyről a 6. helyre került a kanyarójárvány által érintett romániai megyék rangsorában.
A járvány Románia 38 megyéjét érintette, vagyis szinte az egész országot. Továbbra is Krassó-Szörény, Temes és Arad megyében tartják nyilván a legtöbb beteget. Romániában azt követően jelent meg a kanyarójárvány, hogy a szülők tömegesen kezdték megtagadni a betegség elleni vakcina beadatását gyermekeiknek.
A bukaresti egészségügyi minisztérium a héten társadalmi vitára bocsátott egy oltástörvény-tervezetet, ugyanis jelenleg nem létezik ilyen jogszabály. Ezáltal is felelősebbé akarják tenni a szülőket, hogy ne mulasszák el a vakcina beadatását gyermekeiknek.
Nemzetközi hadgyakorlatot rendeznek a Brassó megyei Nagysinken május 7–23. között, amelyre vasárnaptól kezdődően több szövetséges országból érkezik haditechnika – közölte a román védelmi minisztérium (MAPN).

A jövő héten a hőmérséklet megközelíti majd a 27 Celsius-fokos maximumot, ami meghaladja az ilyenkor szokásos átlagot – közölte Meda Andrei, az Országos Meteorológiai Szolgálat meteorológusa az Antena 3 televízióban.

A Kolozs megyei egészségbiztosítási pénztár a Krónika kérdéseire válaszolva közölte: tudnak az európai egészségbiztosítási kártya kézbesítési késedelmeiről, melyek nem abból adódnak, hogy intézményi szinten késve dolgoznák fel a kérelmeket.

A korábbi RMDSZ‑vezető a fűnyíró kését próbálta megélezni, amikor a gép rázuhant.

Széll Lőrinc eddigi alprefektus személyében magyar prefektust neveztek ki Hunyad megyében.

Milyen lehetőségek nyílhatnak a majdnem egy évvel ezelőtti parajdi bányakatasztrófa után a térség turizmusának tovább éltetésére? Parajd jócskán megcsappant idegenforgalmának potenciális lehetőségeiről dr. Horváth Alpár egyetemi oktatót kérdeztük.

Tragikus hirtelenséggel meghalt Takács Csaba, az RMDSZ egykori ügyvezető elnöke. A gyászhírt Kelemen Hunor szövetségi elnök tette közzé közösségi oldalán.

Csütörtöki ülésén fogadták el Arad megye költségvetését. Kidolgozásánál figyelembe vették a RMDSZ-es vezetésű önkormányzatok, a jelentős számban magyarok által lakta települések, a magyar történelmi egyházak és a magyar civil szervezetek igényeit is.

Súlyos szabálytalanságok sorát tárták fel a rendőrök Máramaros megyében, amikor egy traktort ellenőriztek Jód településen: a járművezető jogosítvány nélkül, ittasan vezette a járművet, miközben igazolatlan eredetű faanyagot szállított.

Különleges utazásra hívják az erdélyi tájak és a vasút szerelmeseit Szeben megyében május elsején és másodikán: gőzmozdony vontatta szerelvényen utazhatnak a kisvasúton, amelyet románul „mokanicaként” emlegetnek.
